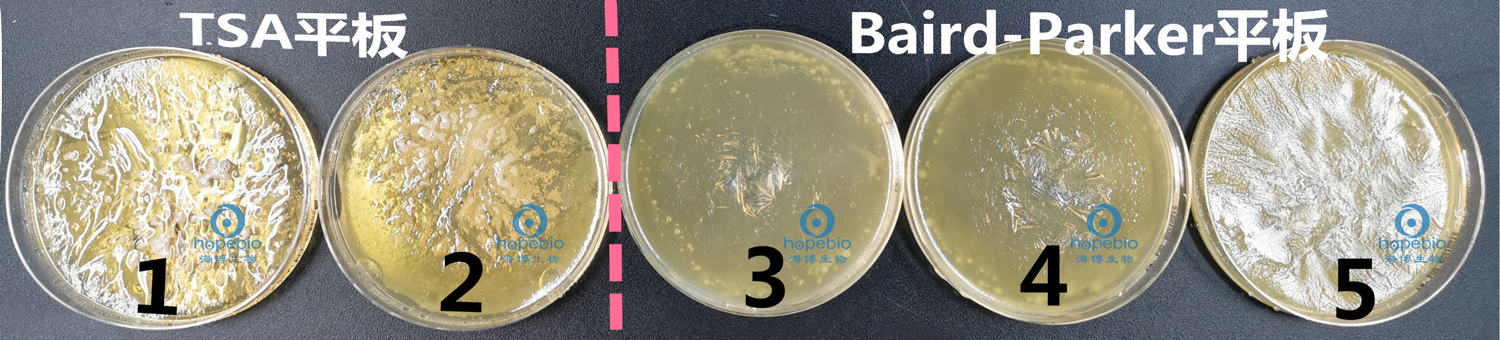
培养基失效的预防措施,平板被冻坏了怎么办

一、背景简介
细菌培养是食品、药品、化妆品及临床领域常见的细菌检定和分离的手段,使用各种培养基平板能够使用户方便快捷地进行微生物培养和分离工作。随着人们对食品、药品、安全健康等方面的日益重视,各大医院、疾控中心及食品药品检验单位都需要用到大量的培养基平板。
培养基的发展历程在经历了从用新鲜组织配制到脱水干粉培养基的转变之后,又发展成颗粒培养基,深得用户好评,但不论干粉还是颗粒培养基,都需要使用者亲自配制,中间要经过称量、溶解、高压灭菌、倾倒平皿甚至后期保存等步骤,耗费大量的人力物力和时间。
顺应市场需求,一次性使用即用型平板诞生了。由专业的培养基生产厂家批量生产出培养基平板,用户只需根据需要选购即可。既可随用随买,又可根据需要适量保存一些,需要时直接取用,非常方便。
二、问题反馈
商品化的即用型培养基平板一般采用真空包装,保存条件比较宽泛,通常放置在2-25℃均可(如图1)。但是未经包装或是已经拆开包装的即用型平板,是需要放置在冰箱中冷藏的。

图1 即用型培养基平板保存条件
为此,经常有客户询问,TSA平板,放4℃冰箱冷藏,拿出来用的时候,发现已经冻住了,严重的会完全冻成冰碴状,导致无法使用,却不知道怎么回事。本文主要针对这一问题进行探讨。
三、原因探究
首先,培养基放在4℃冰箱冷藏,这是正确的,但是有个前提,必须保证冰箱中的温度是稳定且均匀的。至少平板所在的位置,温度应该是符合要求的。但是,这只是理想状态,实际使用的冰箱,我们通常说4℃冷藏,并不是严格的4℃,而是设置在3-8℃之间,在这个区间内,培养基平板是不会结冰的,但是还会有其它很多因素,导致冰箱内部或局部温度过低。比如:
1、冷藏室温度设置过低
冰箱冷藏室通常正常温度是在3℃到8℃之间。若是冰箱冷藏室的温度设置过低,箱内就容易出现结冻现象。所以使用冰箱的时候,要谨记冷藏室温度设置在一个适宜的温度范围内。
2、冰箱门密封条不紧密
冰箱门上面都有密封条,是为保障冰箱外的热空气不进入冰箱内,保障冰箱内的温度恒定而设计的。若是冰箱门上的密封条不紧密,就会致使冰箱外热空气流向冰箱内,而碰到温度低的冰箱时,热空气就会凝结成水,进而致使冷藏室结冻。故冷藏室结冻,要谨记仔细检查一下冰箱密封条,查看其是否松动导致结冻。
3、温控器故障
温控器是调控冰箱冷藏室温度的关键,若是控温器自身有故障,致使压缩机很长一段时间工作不中断。这样就会致使冰箱室内的温度持续下滑,进而致使冰箱结冻的现象出现。
4、平板与制冷机距离过近
冰箱冷藏室制冷的时候后壁结霜,将平板摆放在冰箱冷藏室后壁位置,过于贴合后面的内胆,因为后背有制冷管的缘故,就会导致结冰现象出现。
直冷式冰箱的蒸发管就紧贴在冰箱内壁,蒸发管的温度不会控制到温控器设定的温度,肯定会更低,玻璃置物板因为导热更快,它的温度也可能会低于0℃。冷空气下降,冰箱底层空间的温度也可能较低。
总之,只要出现平板冻坏,一定要先检查冰箱的温度及平板在冰箱中的保存位置。
下面的试验是模拟冰箱中的培养基平板冻坏的情况:
(1)分别将TSA平板和Baird-Parker平板放置在冰箱的不同位置,靠近门的地方标记为“外”,靠近最内壁的地方标记为“里”,放置24h后取出(如图2)可以看出,靠近后壁的平板有明显的冻过的痕迹(红圈圈出的),而靠近外侧的平板,则状态正常。

图2 在冰箱中不同位置冷藏的平板状态
(2)再将5个平板叠放在-20度冰箱,24h后取出,可以看到平板全部冻坏了,就是客户通常所说的冰碴状。尤其是最上层和最下层的平板尤其严重(图中1、2、5),而靠近中间位置的平板,冻坏的程度稍轻一些(图中3、4,客户碰见的通常是这种)。
图3 经过冷冻处理的平板状态
毫无疑问,出现这种情况,并不是平板本身的问题,而是温度的影响造成了平板冻坏,即使加热溶化后重新倒平板,里面的成分也发生了未知的变化,不能再用了。
四、预防措施
结合试验分析及冰箱使用的知识,为了避免培养基平板被冻坏,应注意以下几点:
1.将冰箱冷藏室温度设置在一个适宜的温度范围内;
2.平板一定不要紧贴冰箱内壁放置;
3.冰箱内物品堆放不要太满;
4.未开封的平板,可以放置在温度稍高的地方(2-25℃均可),不用严格4℃冷藏;
5.已经开封的平板,尽快用完,即使冷藏,也不要长时间放置;
6.冬季给寒冷地区(东北地区)的客户发货时,要做好保暖防护;
7.建议寒冷地区的用户,根据季节合理安排即用型平板的订购和备货,尽量避开寒冬期。
TSA培养基平板(9cm)-产品详情:
http://www.hopebiol.com/asphtml/product2205.htm
Baird-Parker琼脂平板(9cm)-产品详情:
http://www.hopebiol.com/asphtml/product2190.htm
注:本文属海博生物原创,未经允许不得转载。